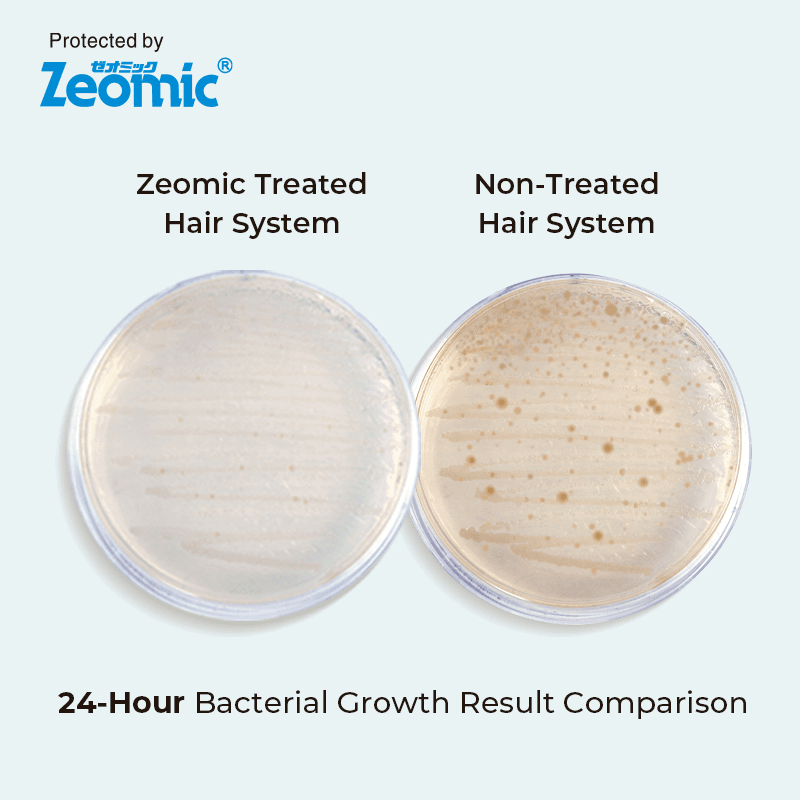

Zeo-Helios | Antimicrobial Hair replacement system
Couldn't load pickup availability
Description
ZEO-HELIOS:Full Lace System with Antimicrobial Protection
Designed for breathable daily comfort — with added hygiene support.
Why Choose Zeo-Helios?
Zeo-Helios combines maximum breathability with antimicrobial protection for confident daily wear.
- Full Swiss lace base allows heat and moisture to escape easily
- Hand-tied hair creates realistic movement and flexibility
- Bleached front knots (except #1 and #1C) help achieve a clean, exposed hairline
- Zeoguard technology supports a fresher, more comfortable wear environment
- Expected lifespan: 4–5 months with proper care
Zeo-Helios is ideal for men who want lace comfort with added peace of mind.
Who Zeo-Helios Is Best For
Zeo-Helios is an excellent choice if you:
- Sweat regularly or live in warm, humid climates
- Wear your system for long hours and prioritize scalp comfort
- Prefer a breathable lace base with hygiene-focused protection
- Want a natural hairline suitable for everyday exposed styles
When Zeo-Helios May Not Be the Best Choice
Zeo-Helios may not be ideal if you:
- Prefer a skin base for a more scalp-like appearance
- Want extremely dense, high-volume hairstyles
- Need bleached knots in colors #1 or #1C
- Require maximum stability under intense sweat and movement
For an invisible skin-based finish, consider Upgrade Mirage or Zeo-Mirage.
For stronger performance in high-sweat conditions, a hybrid system may be a better fit.
Product Specifications
Shipping & Returns
Shipping
- US Ground 5-7 Business days $14.99 (Free with your purchase over $179)
- International 7-10 Business days $29.89 (Free with your purchase over $249)
*Please note that international shipping cannot be upgraded.
*Business days refer to Monday to Friday
Wholesale Accounts
The shipping charge for bulk wholesale orders is $30 for 1 piece, plus $3 for each additional.
Returns
Returns and exchanges are accepted within 45 days from the delivery date. We offer three return options for you to choose from.
*conditions applied
If you have any questions or concerns, please contact us anytime.
See our Shipping Policy & Return Policy for more details.